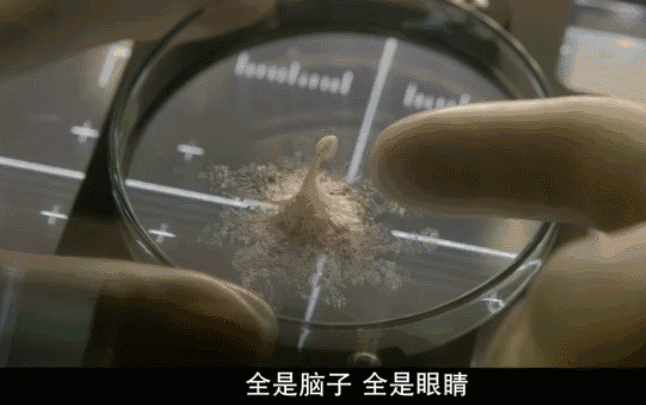

跟爱几道菜一样,大多数影迷可能都有自己爱看的几个系列电影。
所谓系列电影,一而二,二而三,三而无穷。
能一边生活着,一边看喜欢的电影一直讲下去,也未尝不是一件幸事。
“古老”的《星球大战》是这样,前不久的《金刚狼3》也是如此。40句充满正能量的经典励志语录
看完一部精彩的电影,对它最大的褒奖就是希望能出续集。
我认真的,今天讲的这部电影,你不出续集我和你没完——
《异星觉醒》
Life

希望一部电影出续集,并不仅仅是单纯因为喜欢。
而是这部电影,从各方面来讲,都有出续集的潜质。
试问一部能出续集的电影,应该具备怎样的特质?
首先主角要够扎实,这里的主角有两层,一是主演,二是角色。
《异星觉醒》演员阵容还对得起期待它的观众的。
主演杰克·吉伦哈尔实力有口皆碑,数次提名包括金球奖、英国电影学院奖最佳男主角提名。
这次在《异星觉醒》里扮演宇航员大卫,基本贯穿全片故事走向。最关键的是,如果拍续集,这一位将是最重要的角色之一。

电影扎实的演员不只这一位,是一班子。
塑造过经典的007女郎角色的丽贝卡·弗格森这次出演了重要角色,你们要是还记得那张经典的剧照,就一定知道这次也不会让你们失望。

《谍中谍5》剧照
丽贝卡这次出演了船长莫瑞达,一个略悲情的角色。

“死侍”瑞恩·雷诺兹的加入也很让人意外,电影中虽然戏份不多,但是也是个极具英雄色彩的角色了。

日本演员真田广之可能大家不是非常熟悉。

但是陈凯歌电影《无极》里的将军想必大家都是熟的。

《无极》剧照
《异星觉醒》走的是系列电影最会走的“团队模式”,一个团体的宇航员对战“异星物种”,中间精彩与曲折可想而知。
当然了,说到角色就不得不说反派角色。反派角色如何成就了系列电影的精彩,从《星球大战》的帝国军到《生化危机》的生化丧尸们,他们的威力我们有目共睹。
《异星觉醒》反派角色凯文,基本呈现了一个单细胞生物的进阶之路。
从一个细胞。

到一个“萌萌的”小生物。
再到一个摧毁意识觉醒,威力渐显的反派,一步步叩击人心。

基本电影百分之八十的情节推动,就来自这个异星生命凯文,由弱到强的过程毫不含糊。
这部电影在如此的角色构成下,很好的塑造了一出太空背景下的封闭空间惊魂记。
这也是它具有的另一个系列电影潜在特质,就是完整塑造了既定时空下的文本呈现。
这一点很好理解,系列电影《饥饿游戏》的打造就是同样的道理。
特定的故事发生背景,既定的空间竞逐。
《饥饿游戏》的重点在于游戏规则下的生死竞争,和乌托邦式的政权更迭。

《饥饿游戏》剧照
它的燃点在于主角对于故事的把控与反转,观众想看的是人在这个特定大环境下的力量。
而《异星觉醒》从大的角度上来讲,也塑造了一个特定的环境,那就是这个漂浮在星际的太空船。

但它燃点的不同在于,主角们对抗的不是一个既定的反派。这个反派是未知的火星生命,它能否醒来,是好是坏,摧毁力或者是影响力多大,都不得而知。
在一个封闭的太空船空间里,一群宇航员面对的却是未知的,这样的设定明显比《饥饿游戏》更加吸引人,而很明显,故事的后续更值得期待。
它的续集价值也同样可想而知。

而且在这样的背景下,《异星觉醒》对科幻、惊悚的元素应用也到位。
太空船内一切超出地球常规的行事准则和科幻元素,反而衬托了整个故事的惊悚意味。
两相映衬,分外有味道。

近几年,科幻、太空类型电影越来越多,从“古老”的《星球大战》开始,电影作品都开始探索这一领域的精彩,其实这也是观众的兴趣的一种折射。
这些电影在科幻、太空的分类之下,还有“花开几朵,各有千秋”的呈现。
其中有《星际穿越》的哲学思考,也有《银河护卫队》的瑰丽想象,当然也有《世界之外》这类披着科幻外衣的小清新爱情。

《世界之外》剧照
但是能出续集的,无一例外主题够宏大。《异星觉醒》本身对宏大主题的探讨,就让它具有了这种潜质。
太空船的起航本身意义就在于探索生命的更多未知,当一个来自火星的物质来到他们的太空船,他们首要的任务和使命当然是科研。

在“异星”觉醒之后,如何看待它和与它共处,是一回事。
而如何辨别其善恶和潜在的能量,又是另一回事。
一场外太空的生命探索之旅,其实诘问的是人类该不该以探索未知生命为己任。
电影里,宇航员、科学家们与凯文的对抗,客观呈现了多种不同对待这个问题的态度。
恼羞成怒的“死侍”要赶尽杀绝。

而视凯文如己出的科学家,却甘愿用自己来喂它。他是从新生命的角度面对凯文,反而抛却了自身的生死。

到底聚焦自身死活拒绝新生命的一切可行性,还是为了生命更多未知的领域选择探索?
这个问题放在一群宇航员和科学家身上,就显得格外意味深长。
这也是它具有系列电影潜质的根本原因,系列电影从来不是一个“单本”战略。
在第一部够确切的角色塑造、主题展开的基础上,才可能在一个故事基础上扩充出更多引人遐想和期待的“多本”故事。

《异星觉醒》作为一部科幻电影,集合惊悚元素和对生命议题的逐层递进思考,节奏紧凑主题精准,最关键的是主要角色的命运去向真的挺让人期待的。
电影结局不剧透,但毫无疑问,它已经撒下了“多本”故事的大网。5月19日,大家可以去影院感受一下。
对于这个结局我也只想说,你不出续集,对得起谁?

娱乐圈中被包养的女星数不胜数,包养男人的女星也数不胜数,但是很多女星被包养后还死 ...
讲到女性做爱至高潮算得上是一件很神秘的事情,因为男女之间的区别,男性在高潮时伴有 ...
近日,一美国19岁女孩在图书馆里面不管不顾公众场所,公然自慰事件引起了网友们的关注 ...
昨天,院长写了一篇关于电影《大只佬》的原版解析。这部当年囊括23届金像奖多个奖项的 ...
据韩国媒体日刊体育报道,《RunningMan》改版,金钟国被裁,宋智孝也被节目组抛弃。宋 ...